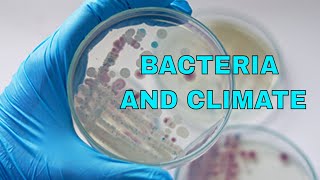

Rise in flesh eating bacteria linked to climate change video
Online izle ve mp4 mp3 formatlarinda yukle

Videonun muddeti: 0:29
Rise in flesh eating bacteria linked to climate change videosu mp4 ve mp3 yuklemek ucun hazirdir
Diqqet! Siz Mp4 yukle ve ya Mp3 yukle duymesine basdiqdan sonra eger sistem sizi reklam sehifesine atarsa o zaman derhal geri qayidib emeliyyati tekrar edin ve faylin yuklemek ucun hazir olmasini gozleyin
Videodan Mp4 Yukle
Videodan Mp3 Yukle-1
Videodan Mp3 Yukle-2
Oxshar Axtarishlar
 Rise in flesh-eating bacteria linked to climate change
Rise in flesh-eating bacteria linked to climate change Warming Climate Linked to Rise in Flesh Eating Bacteria in U S Waters
Warming Climate Linked to Rise in Flesh Eating Bacteria in U S Waters Flesh-eating Bacteria Rise Could be Due to Climate Change
Flesh-eating Bacteria Rise Could be Due to Climate Change Increase in flesh-eating bacteria may be caused by climate change
Increase in flesh-eating bacteria may be caused by climate change Doctors say more people will contract a flesh-eating bacteria because of climate change
Doctors say more people will contract a flesh-eating bacteria because of climate change Climate change increasing risk of contracting flesh-eating bacteria, doctors say
Climate change increasing risk of contracting flesh-eating bacteria, doctors say FLESH EATING BACTERIA!!! #climate #environment #hurricane #bacteria #change #news #learning #future
FLESH EATING BACTERIA!!! #climate #environment #hurricane #bacteria #change #news #learning #future Potential fatal bacterial infections rising due to global warming, scientists say
Potential fatal bacterial infections rising due to global warming, scientists say Flesh-eating bacteria cases on the rise | FOX 5 News
Flesh-eating bacteria cases on the rise | FOX 5 News
Video Mp4 Mp3Azwap.Biz
Azwap.Biz 2021-2023


 Rise in flesh-eating bacteria linked to climate change
Rise in flesh-eating bacteria linked to climate change Warming Climate Linked to Rise in Flesh Eating Bacteria in U S Waters
Warming Climate Linked to Rise in Flesh Eating Bacteria in U S Waters Flesh-eating Bacteria Rise Could be Due to Climate Change
Flesh-eating Bacteria Rise Could be Due to Climate Change Increase in flesh-eating bacteria may be caused by climate change
Increase in flesh-eating bacteria may be caused by climate change Doctors say more people will contract a flesh-eating bacteria because of climate change
Doctors say more people will contract a flesh-eating bacteria because of climate change Climate change increasing risk of contracting flesh-eating bacteria, doctors say
Climate change increasing risk of contracting flesh-eating bacteria, doctors say FLESH EATING BACTERIA!!! #climate #environment #hurricane #bacteria #change #news #learning #future
FLESH EATING BACTERIA!!! #climate #environment #hurricane #bacteria #change #news #learning #future Potential fatal bacterial infections rising due to global warming, scientists say
Potential fatal bacterial infections rising due to global warming, scientists say Flesh-eating bacteria cases on the rise | FOX 5 News
Flesh-eating bacteria cases on the rise | FOX 5 News